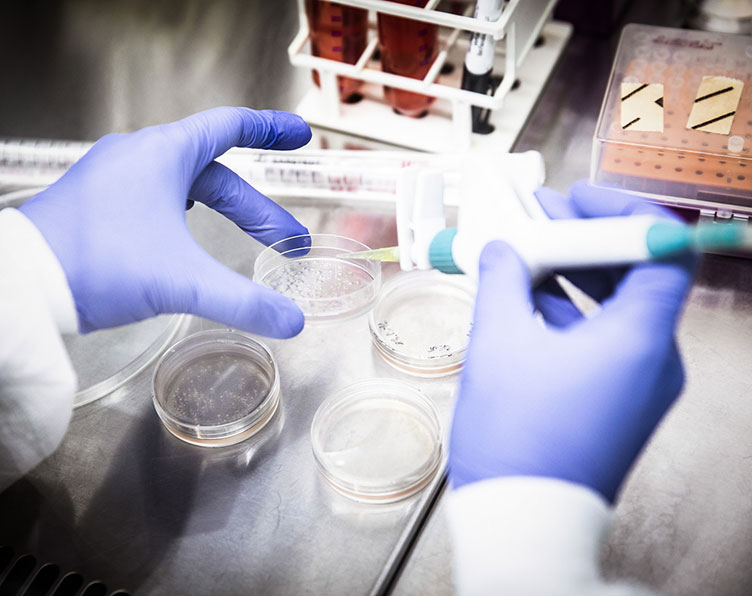

Compelling photography conveys the passion and dedication of everyone on campus, the pursuit of scientific discovery, and the unique spirit of ISTA. This section details how to capture and use imagery and video as part of the ISTA brand.
Photography and videography should feel natural and candid while still conveying polish and professionalism. Bright, natural light is ideal whenever possible. Focus on the subject(s) while still giving a sense of the surroundings, secondarily showcasing the spaces throughout campus, both indoors and outside.
Images should illuminate moments of connection.
Look for opportunities to showcase ISTA’s core attribute of connection: between two colleagues, between a scientist and their work, between a professor and a PhD student, between campus and nature, between two or more perspectives. This helps to tell the ISTA story and conveys the compelling nature of the energy and enthusiasm on campus.

Consider the following recommendations when creating new images or video for ISTA. Share these principles and guidelines with a contracted photographer or videographer. Look for these attributes when selecting images from the ISTA library. Stock photography should be avoided whenever possible but when you must use it, look for similar characteristics as listed below so they feel cohesive with the rest of the imagery.

Bright, natural light. Even when shooting indoors, aim to position subjects as close to a window or natural light source as possible. Generally, images and videos should feel light-filled and natural — avoid heavy shadows. overexposure, or harsh highlights.

Unexpected compositions. Try placing subjects slightly off-center, using open space to frame a focal point, or cropping in an unusual way to create more compelling compositions.

Engaged scientists. Lab settings and scientific equipment should play a secondary role to the scientists themselves (unless the goal of the image is to showcase the lab, for example). Highlight the passion, enthusiasm, and/or focus of ISTA scientists.

Connected colleagues. Photos and video should capture genuine moments of connection and camaraderie between ISTA scientists, students, and staff.

Modern campus. Use architectural features, green spaces, campus art, or unique spaces around campus to relay a sense of life at ISTA.

Brand colors. When possible, capturing one or more of the brand colors in images or videos is an effective way to bring cohesion and consistency to the brand. (This is not a filter, but the actual light color of the plant lab.)
Tip
When arranging a video or photoshoot, ask your participants to wear any color they prefer except for solid black or white (as it is more difficult to see detail) and to avoid busy patterns or large logos/graphics. Subjects should feel comfortable but not wear anything that may be distracting.

Do not use images with old logos or former ISTA brand marks. If the image is still relevant, remove the previous logo using Photoshop.

For photos and videos, avoid dim or dark lighting, unnatural lighting, and color filters.

Do not desaturate images or use grain/noise filters. Keep images natural, bright and crisp.
Black and white photography can be used on occasion, especially for events or a speaker series. It is an effective way to unify portraits or images that come from different sources (i.e. supplied by speakers). Images can be combined with patterns or graphics, as shown below, to bring a pop of color or tie in the photography with the rest of the branded materials.
When shooting portraits, the key light should illuminate the subject to emulate bright, natural light, while fill lights can be used as needed to soften shadows and contrast. Opt for white or light backgrounds whenever possible to avoid distraction from the subject. Portraits will likely be shot in color and then changed to black & white in post-production.



(Above examples were created using stock photos.)
One of the most amazing things about ISTA is our diversity. We have students, faculty, and staff with citizenships from over 80 different nationalities. And with that diversity comes a wide range of perspectives and experiences that ultimately result in unexpected conversations and scientific breakthroughs. We encourage and treasure that interconnectedness and we want to represent it in our photography and video content.
Our diversity extends well beyond geographical borders and includes age, gender identity, sexual orientation, religion and spiritual beliefs, disability, socioeconomic status, cultural background, and neurodiversity.
All imagery and videos should endeavor to authentically share this inclusivity commitment with our audience.
Here are additional resources that may be helpful:
Guidelines (for verbal and visual references) related to gender and gender identity.
Published by the Austrian Press Agency in Jan 2025. Downloadable PDF.
Published by UPAA.org in Feb 2022. Downloadable PDF.
If you have questions, contact ISTA’s Equity, Diversity and Inclusion Office.
Combining photography with the other graphic elements adds variety and interest to the ISTA brand and makes images truly unique. Overlaying one of the patterns, combining with brand colors, and/or using a block- or grid-based frame are some of the options to add a layer of depth and memorability to imagery. Patterns can be downloaded here.

This example uses a brand color that closely matches the image as both a framing element and pattern overlay.

A unique photo frame is created by combining block shapes (from the ISTA logo) and using it to mask an image.

Overlaying a pattern in the same color as the background allows the image to feel integrated and adds a unique level of sophistication.
Copyrights
When using images and/or video, be sure to give credit to the photographer, videographer, or author of the work using the © symbol and the appropriate name or agency. This can be included in the image caption (the preferred placement), in small type near the image or video, in the caption or comments on social, or included with other credits/copyright information on a website or printed piece. If a staff member of ISTA provided the image or video, include: © ISTA.
Images used in this guide include: © Nadine Poncioni/ISTA, © Peter Rigaud/ISTA, © Kurt Kuball/ISTA, © Magic Lemur Productions/ISTA, © ISTA